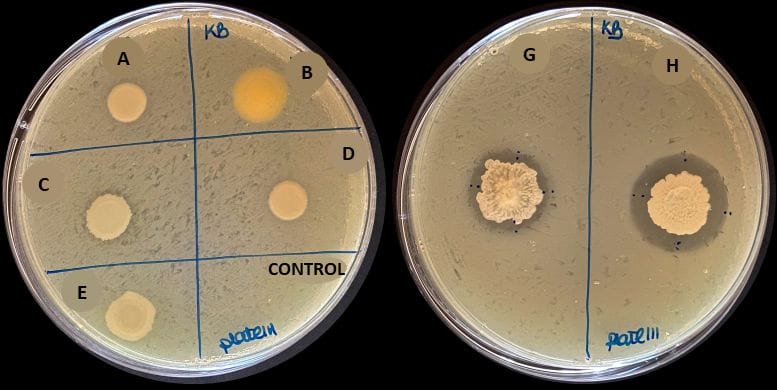

Como parte da sua estratégia para o desenvolvimento de produtos bio-inspirados, o InnovPlantProtect (InPP) está a contruir uma biblioteca de micro-organismos isolados de diversos ambientes, que estão a ser identificados por caracterização molecular e avaliados relativamente às suas propriedades bioquímicas, indicadoras de potencial função como Agentes de Controlo Biológico (BCA, na sigla inglesa). Em paralelo, o InPP está a contruir um portefólio de agentes fitopatogénicos (bactérias e fungos), que servirá de base para a avaliação in vitro e in vivo do potencial dos BCA isolados.



Segundo a Organização das Nações Unidas para a Alimentação e a Agricultura (FAO, na sigla inglesa), cerca de 40% da produção agrícola global é perdida anualmente devido a pragas e doenças, o que se traduz em perdas de mais de 195 mil milhões de euros. Há décadas que os fitofármacos têm um papel fundamental na manutenção da sanidade agrícola, protegendo as culturas contra pragas e doenças, e garantindo a segurança alimentar. No entanto, o seu uso excessivo, e por vezes inadequado, tem um impacto negativo no solo, na água e na biodiversidade, podendo ter efeitos prejudiciais na saúde de animais e de seres humanos.
Como parte da estratégia “Do Prado ao Prato”, um dos pilares do Pacto Ecológico Europeu, a Comissão Europeia definiu metas para o uso sustentável de fitofármacos, uma das quais estabelece a redução da sua utilização em 50% até 2030. Para fazer face à saída do mercado destes produtos, é necessário desenvolver alternativas eficazes, sustentáveis, amigas do ambiente e económicas.
Uma dessas alternativas é a utilização de BCA. Estes micro-organismos são eficientes na redução da incidência ou gravidade de doenças causadas por agentes fitopatogénicos, atuando também alguns como bioestimulantes, ou seja, tendo a capacidade de aumentar a robustez e a velocidade do desenvolvimento das plantas.
Há diversos mecanismos através dos quais os BCA exercem a suas funções, nomeadamente: induzindo mecanismos de resistência na planta; competindo com os agentes patogénicos por espaço e nutrientes; interagindo através de mecanismo de antibiose (em que um organismo prejudica o desenvolvimento do outro); segregando compostos antimicrobianos ou antifúngicos; e invadindo e/ou matando células dos agentes fitopatogénicos.